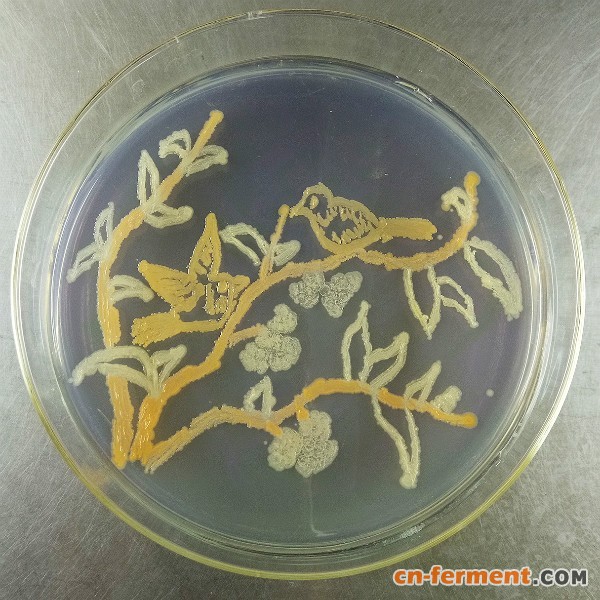
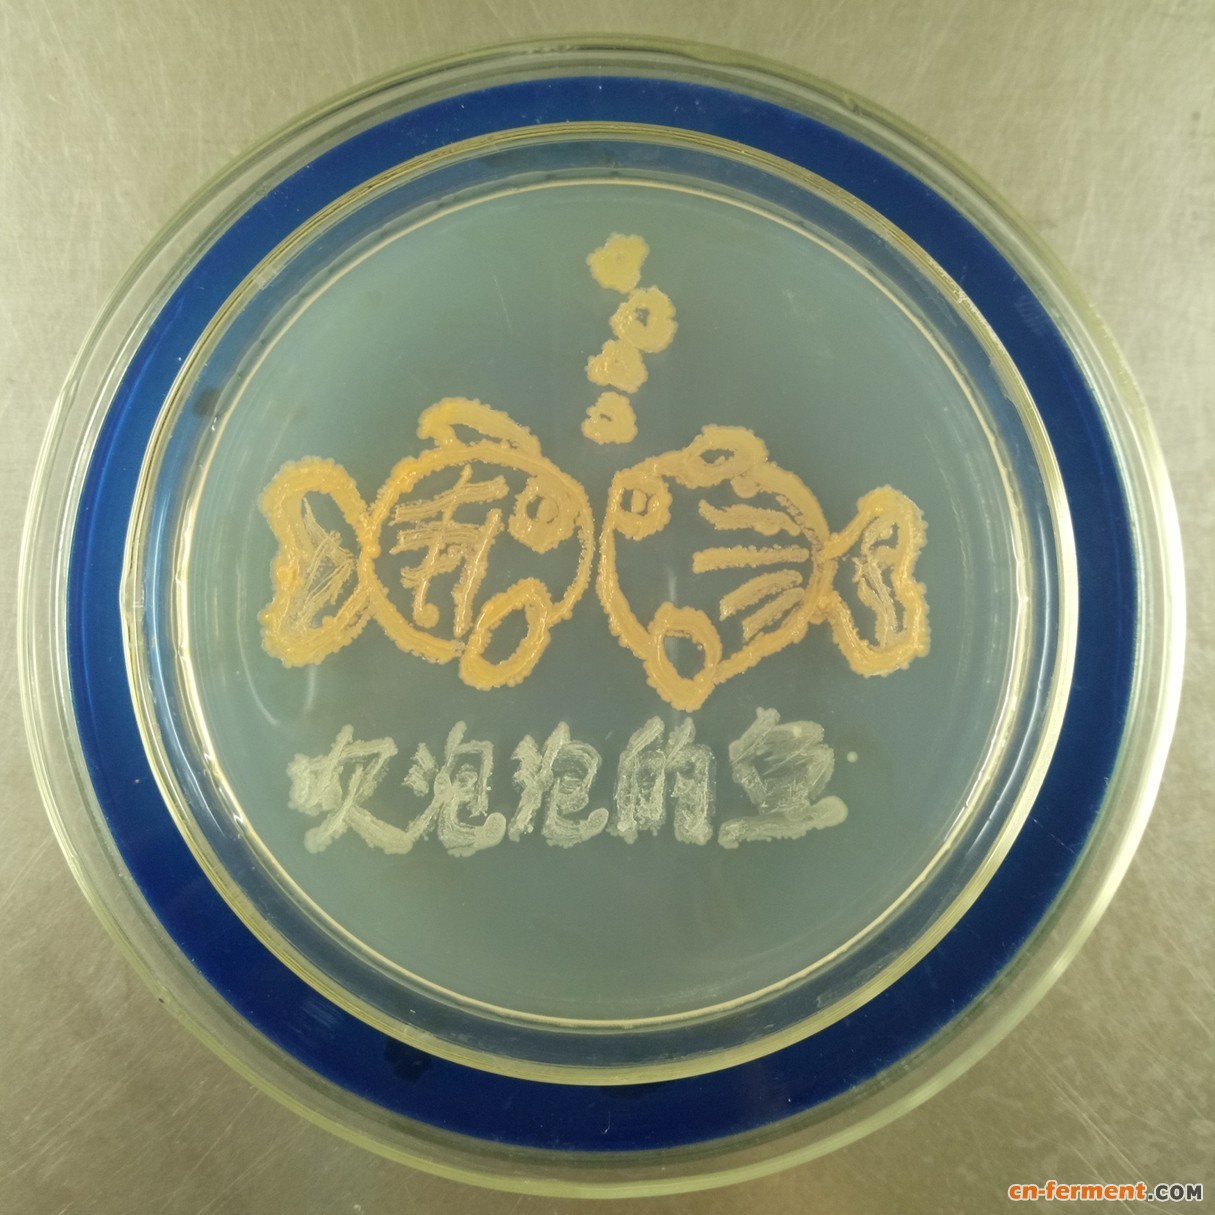
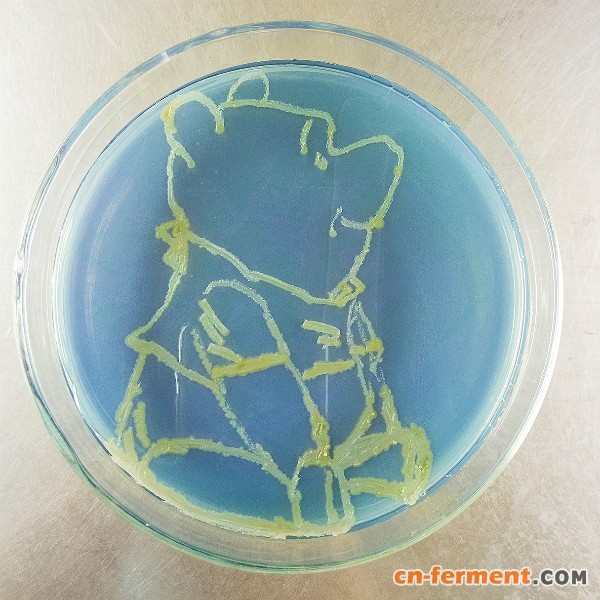
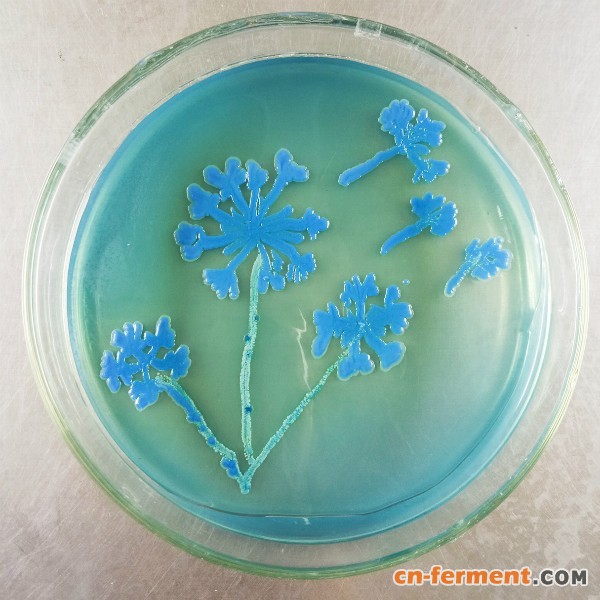
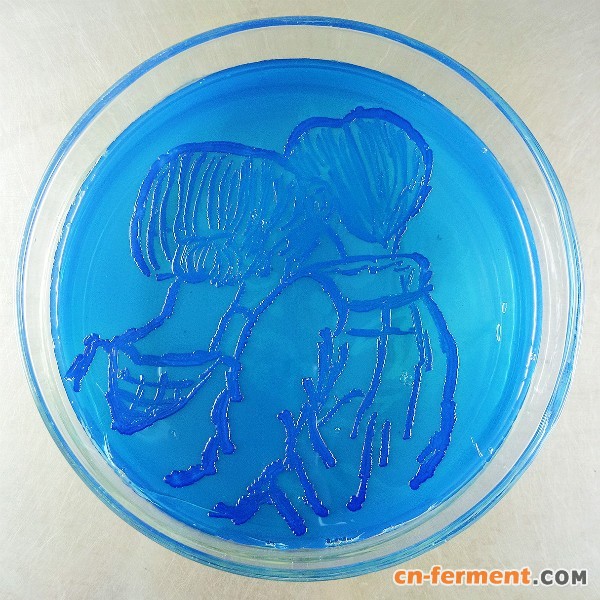
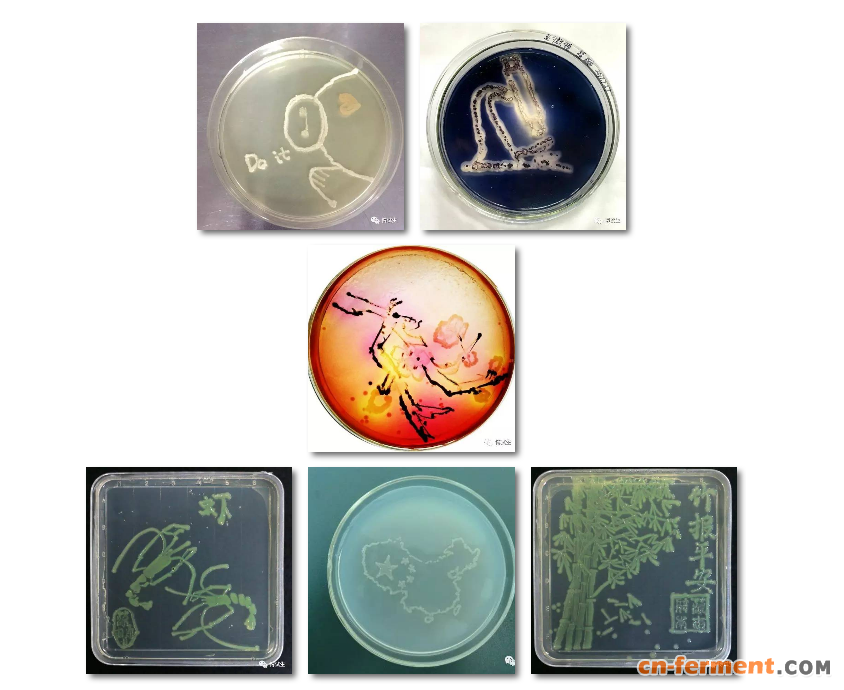

To see a World in a Grain of Sand
一粒沙里有一个世界
And a Heaven in a Wild Flower,
一朵花里有一个天堂
Hold Infinity in the palm of your hand
把无穷无尽握于手掌
And Eternity in an hour.
永恒宁非是刹那时光
——英国诗人威廉·布莱克(William Blake)(1757-1827)著,台湾的散文家陈之藩译。
一群微生物,一个培养皿,发挥你的想象力,方寸之地,也会创造出一个充满生活和艺术的世界。
中国微生物学会主办、安琪酵母承办的“第一届中国微生物培养皿艺术大赛”报名投稿正在火热进行中,美轮美奂的作品创意和艺术水平超越我们想象,以下仅选择来自参赛选手梁鑫鑫的系列作品供大家欣赏。
早安,你好
会吹泡泡的鱼

生如夏花
小熊维尼

雏菊
蒲公英
呵护

向前进
浓情夏日,由中国微生物学会主办、安琪酵母承办的“第一届中国微生物培养皿艺术大赛”火热来袭,更有万元大奖、年会颁奖等你来,详情请登录http://www.biolabline. com。

博试生为您精心挑选参赛必备产品,菌株、培养基、接种棒任你选,更有贴心优惠等你来拿。
1、标准菌株系列 大赛优惠价8折
2、培养基系列 大赛优惠价9折
3.相关耗材 大赛优惠价9折
火热报名中
赶紧来参加
万元大奖等你拿!




